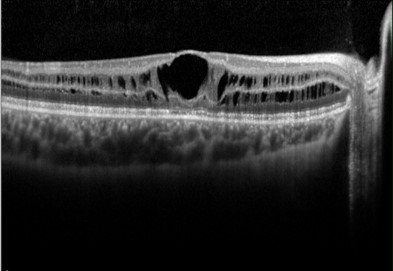

Overview
X-linked retinoschisis is an X-linked, recessive, vitreoretinal disorder caused by mutations in the RS1 gene. The RS1 gene encodes retinoschisin—a protein found in the photoreceptors and bipolar cells, responsible for cell-cell adhesion and cell-matrix interactions.
X-linked retinoschisis has an estimated prevalence of 1 in 5,000 to 20,000 and typically presents in boys before school age. Female carriers are generally normal or show subtle abnormalities.
The characteristic sign of X-linked retinoschisis is a spoke-wheel appearance radiating from the fovea with OCT showing splitting of the neurosensory retina at multiple retinal layers creating schisis cavities. Peripheral retinoschisis is reported in 50-70% of the cases and can lead to complications such as retinal detachment and vitreous haemorrhage.
As the disease progresses, macular cystic changes may disappear, and neurosensory retina thinning ensues. Vision is typically stable in most of the adulthood and deteriorates in the fifth or sixth decade when macular atrophy occurs.
Case Examples
-
Case 1
A 15-year-old male with best-corrected visual acuity of 6/15- (20/50-) in the right eye and 6/19+ (20/48+) in the left.
-
Case 2
A 46-year-old Caucasian male was previously diagnosed with X-linked retinoschisis. He has a strong family history of the condition affecting his uncle, brother, and cousin. His best-corrected visual acuity is 6/38 (20/127) in the right eye and 6/12- (20/40-) in the left. Colour vision was failed with 9 mostly tritan crossings OD and 4 tritan crossings OS with the Standard D-15.
Fundus photographs (right and left eye)
More infoOptomap widefield images (right and left eye)
More infoOptomap image of the Inferior fundus (right eye)
More infoFundus autofluorescence images (right and left eye)
More infoSpectralis OCT macular line scans (right and left eye)
More infoSpectralis OCT line scans through an area of inferior retinoschisis
More info
Differential diagnosis
An additional differential diagnosis not currently covered in this Atlas includes enhanced S-cone syndrome (Goldmann-Favre).
References
George ND, Yates JR, Moore AT. X linked retinoschisis. Br J Ophthalmol 1995; 79: 697-702.
Molday RS, Kellner U, Weber BH. X-linked juvenile retinoschisis: clinical diagnosis, genetic analysis, and molecular mechanisms. Prog Retin Eye Res 2012; 31: 195-212.
Kim LS, Seiple W, Fishman GA et al. Multifocal ERG findings in carriers of X-linked retinoschisis. Doc Ophthalmol 2007; 114: 21-26.
Puech B, Laey J-J, Holder G. Inherited Chorioretinal Dystrophies: A Textbook and Atlas, 2014.


